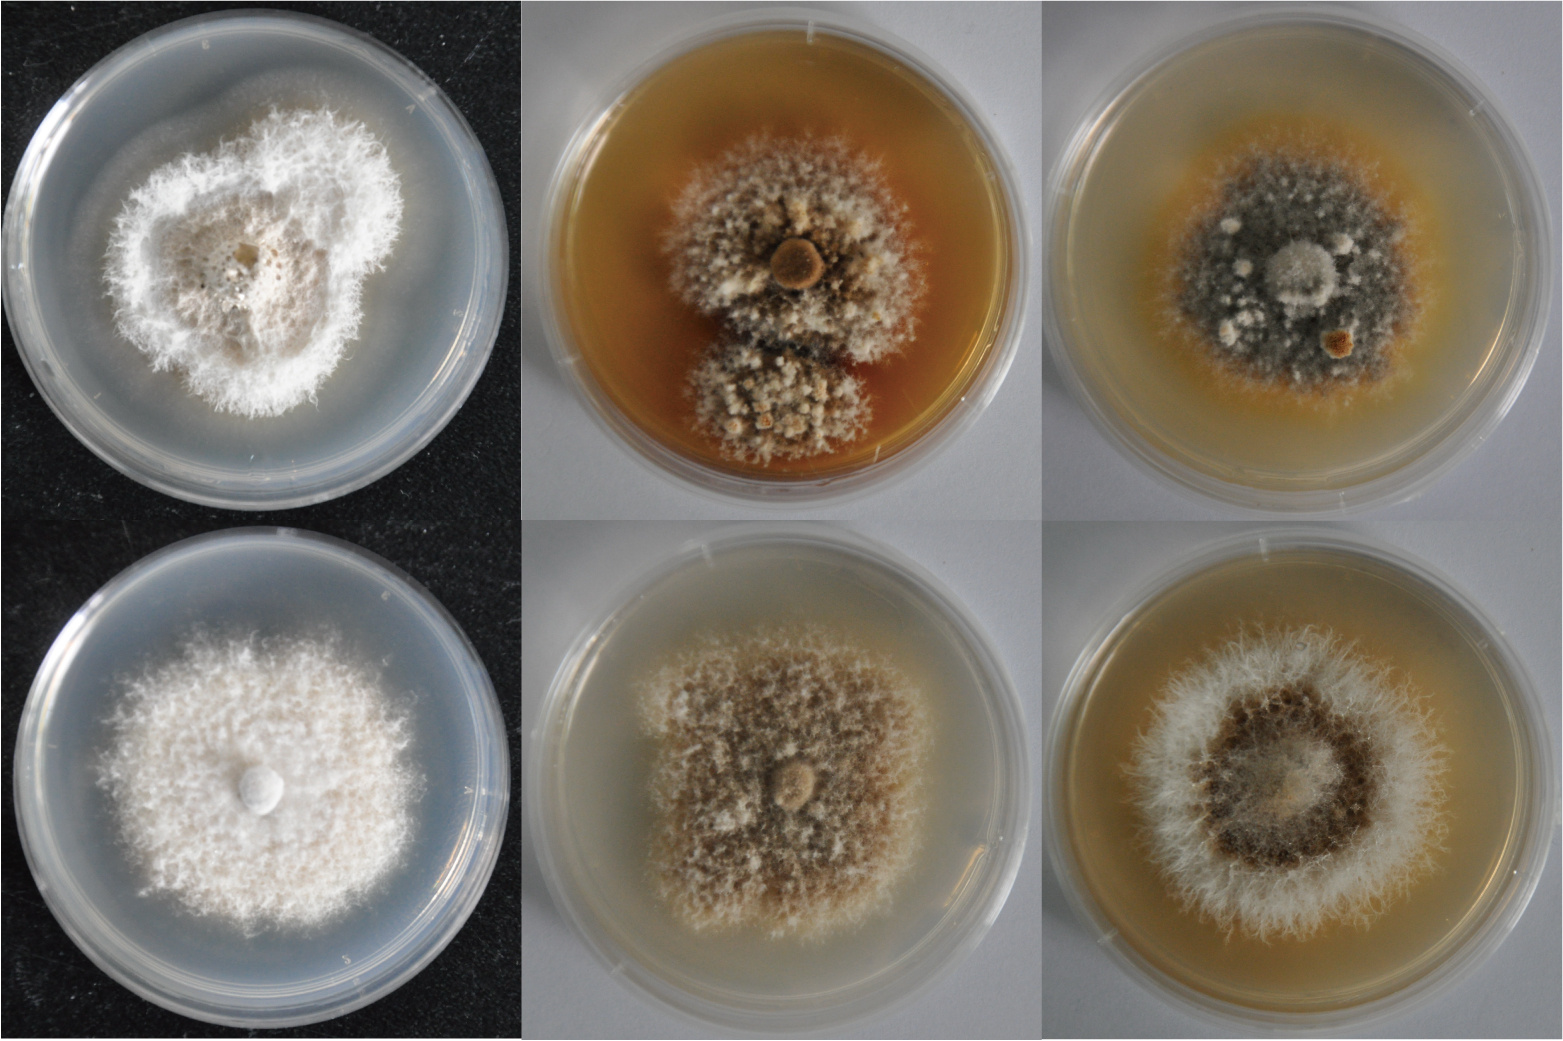

The relict fir tree Abies beshanzuensis hosts a changeable endophytic fungus
Published in Ecology & Evolution

Symbiosis referring to living together in an intimate and often long-term association of two or more dissimilar organisms, is ubiquitous in natural ecosystems. Although the outcomes of symbiotic interactions could range from mutualism to parasitism, the former such as lichens, reef corals, mycorrhizae, and root nodules, is predominant as it provides important ecological services. For instance, approximately 80 to 90 percent of terrestrial plants rely on mycorrhizal fungi (mainly form arbuscular or ectomycorrhiza) to improve nutrient uptake and adapt to stressful conditions. In fact, apart from these belowground root-fungus mutualisms, aboveground plant parts are also colonized by a hyper-diverse array of endophytic fungi (often termed as the “foliar endophytes”, FEs). In the broadest sense, endophytes represent the fungi that occur inside asymptomatic plant tissues. Not surprisingly, species diversity, infection model, and functional properties differ greatly between FEs and mycorrhizal fungi. Production of a series of biologically active secondary metabolites is one of the most remarkable characteristics of FEs, and FEs can use these metabolites as chemical weapons to inhibit plant pathogens or pests. In addition, FEs also acta as pioneering decomposers to initiate the degradation of leaf litter immediately following senescence. Clearly, these traits point to FEs to be both saprotrophic and symbiotrophic. However, the genetic basis of occupying dual trophic lifestyles remains elusive.
We work on an interesting endophyte system to resolve this question. Earlier, we found that the relict fir species Abies beshanzuensis (Pinaceae), which is a critically endangered tree species left from the Quaternary glacial period, hosts Pezicula neosporulosa (Helotiales, Ascomycota) as a FE. Ecologically, fungi within Helotiales play a major role in ecosystems, encompassing saprotrophs, pathogens, and several groups of mutualistic fungi (ericoid mycorrhizal fungi and root dark septate endophytes). More interestingly, FEs belonging to Helotiales often show some degree of host preference, that is, they prefer to colonize Pinaceae hosts. It has been estimated that the helotialean ancestors of Pinaceae endophytes have been co-evolving with their hosts for more than 300 million years. From this point of view, we speculate that P. neosporulosa already has evolved to adopt an endophytic habitat.
We leveraged the comparative genomic, and pan-genomic data to reveal cases of convergent evolution of genomic adaptations to foliar endophytism distinct from plant parasitism, obligate mutualism of mycorrhizal fungi, and saprotrophy. More specifically, we found that the P. neosporulosa genome is characterized by significant gene family expansions related to saprotrophic ability and rich in secondary metabolite biosynthetic genes (smBGs), which are characteristic for unrelated plant-beneficial helotialean such as dark septate endophytes and mycorrhizal fungi. We found two potential genetic determinants of endophytism: cellulose-degrading auxiliary activity family 9 (AA9) and β-1,4 endoglucanase (glycoside hydrolase family 5, GH5), which are richer in plant beneficial helotialean fungi than closely-related pathogenic or saprotrophic relatives. We also witnessed a pronounced standing genetic diversity in P. neosporulosa population with a unique mating system, suggesting sufficient variation for this fungus to evolve in response to environments. Subsequent population genomic analyses identified that at least a dozen genes implicated in cell-wall degradation and smBGs are subject to balancing selection, underpinning their evolutionary importance for endophytic niche fitness. Overall, these results expand understanding of the evolution of the endophytic trophic guild of P. neosporulosa, pointing to its rapid convergent adaptation to endophytism and diverse symbiotic interactions.
Read the new paper of Pezicula neosporulosa associated with Abies beshanzuensis here: https://www.nature.com/articles/s41396-021-01176-6

Fig. 1 The aboveground and belowground fungal symbionts associated with Abies beshanzuensis. a: FEs colonize needle tissues intracellularly and produce conidia in vitro. b: Morphology of ectomycorrhizal roots (the composition of ectomycorrhizal fungi is not yet identified).
Fig. 2 Highly changeable colony appearances in P. neosporulosa individuals

Please sign in or register for FREE
If you are a registered user on Research Communities by Springer Nature, please sign in